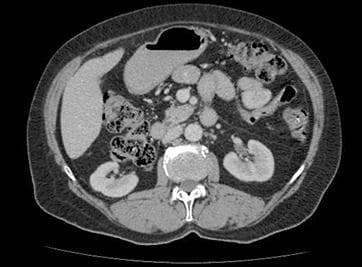
Upper Abdomen CT Scan

Brain MRI
Detailed examination with Brain MRI! Advanced MRI imaging and CT scanning services with expert radiologists. Check-up packages for early diagnosis! Medical imaging center.

With early detection and diagnosis methods, living a healthier life is easier than ever. We offer the following check-up packages with advanced technology devices and experienced doctors at our center.
We offer comprehensive health screening with our MRI, CT, X-Ray, Ultrasound, and Check-Up packages.

Detailed examination with Brain MRI! Advanced MRI imaging and CT scanning services with expert radiologists. Check-up packages for early diagnosis! Medical imaging center.

Discover the cause of your back pain with Lumbar MRI! Fast and reliable MRI imaging service with expert radiologists. Click for medical imaging center options.

Brain arterial angio MRI (MR Angiography) is an advanced magnetic resonance method that provides detailed and non-invasive imaging of the arteries that feed the brain. This examination is of great importance in the diagnosis of stenosis, occlusion, aneurysms, arteriovenous malformations (AVM), and congenital vascular anomalies in the brain vessels. Brain arterial MR angiography is frequently preferred in cases such as headache, dizziness, sudden vision loss, suspected stroke, and transient ischemic attack. It is a safe imaging method as it does not contain radiation. It can often be performed without contrast material, and in necessary cases, vascular structures can be evaluated more clearly with contrast-enhanced brain angiography. Brain arterial angio MRI is more comfortable and risk-free compared to classical angiography. The procedure is painless and usually completed in a short time. Brain arterial angio MRI is an important diagnostic tool for early diagnosis and accurate treatment planning.

Experience superior MR imaging with Temporal MR! Fast, accurate results. Contact us now for expert radiology services and special check-up packages!

Discover the source of your foot pain with a Foot MRI! Contact our medical imaging center for fast and accurate diagnosis with expert radiologists.
Detailed diagnosis with Elbow MRI! Fast and reliable MRI imaging service with expert radiologists. Medical imaging center for early diagnosis.

Discover the source of your shoulder pain with a Shoulder MRI! Visit our medical imaging center for fast and reliable MRI imaging, CT scans, and radiology services with expert radiologists.

Get superior MR imaging, CT scanning, and radiology services with Orbita MR. Discover check-up packages with a reliable medical imaging center!

Detailed medical imaging with Thigh MRI! Expert radiology services and check-up packages for early diagnosis. Reliable medical imaging center.

Examine the health of your baby in the womb in detail with Fetal MRI. Choose our medical imaging center for reliable MRI imaging and radiology services!
Get rid of your pain with Hip MRI! Fast and reliable MRI imaging service with expert radiologists. Early diagnosis, healthy life!

Detailed diagnosis with Hand MRI! Fast and reliable MRI imaging with expert radiologists. Modern medical imaging center. Check-up packages and radiology services.

Secure your lung and chest health with Thoracic MRI! Fast and reliable MRI imaging service with expert radiologists. Book your appointment now!

Examine your sinuses in detail with Paranasal Sinus MRI! Reliable MRI imaging and radiology services for early diagnosis. Check-up packages and CT scan options are available.

Secure your health with an Upper Abdominal MRI! Experience the difference of early diagnosis with our detailed MRI imaging service accompanied by expert radiologists.

Discover the cause of your neck pain with Cervical MRI! Fast and reliable MRI imaging service with expert radiologists. Click for medical imaging center advantages!

Secure your health with a Pituitary MRI! Fast and accurate diagnosis with state-of-the-art MRI imaging, accompanied by expert radiologists. The best radiology services as a medical imaging center.
End ankle pain! Accurate diagnosis and rapid treatment with high-resolution Ankle MRI imaging. Expert radiologists, modern medical imaging center.

Detailed examination with Lower Abdomen MRI! Fast and reliable results with expert radiologists. Discover the power of early diagnosis with the medical imaging center difference!

Discover the source of your pain with Sacroiliac MRI! Fast and reliable MRI imaging service with expert radiologists. Book your appointment now!

Superior MRI imaging with Perfusion MRI! Fast and detailed results for early diagnosis. We are here for you with our medical imaging center expertise.

Detailed medical imaging with Facial MRI! MRI imaging and CT scanning services with expert radiologists for early diagnosis. Visit our medical center for check-up packages and comprehensive radiology services.
Secure your prostate health with Multiparametric Prostate MRI. Superior MRI imaging technology for early diagnosis. With the expertise of a medical imaging center.

Protect your freedom of movement with a Knee MRI! Fast and accurate diagnosis thanks to our modern medical imaging center. Click for radiology services and check-up packages!

Discover the causes of your neck pain with a Cervical CT Scan! Fast and reliable results with expert radiologists. Click for MRI imaging and check-up packages!

Fast and detailed diagnosis with Brain CT! MR imaging and CT scanning services with expert radiologists and advanced technology. Check-up packages with the medical imaging center difference!

Get a detailed view of your sinuses with a Paranasal Sinus CT Scan! Fast and reliable results with expert radiologists. Experience the difference with our medical imaging center!

Secure your lung health with Thoracic CT! Fast and reliable results with expert radiologists. Click for MRI imaging and comprehensive check-up packages!

Discover the cause of your back pain with a Lumbar CT scan. We are a medical imaging center with advanced CT scanning technology and expert radiology services for reliable results.

Detailed examination of the liver, pancreas, gallbladder, and kidneys with Upper Abdomen CT Scan. Advanced medical imaging center and radiology services for reliable results.

Secure your health with a Lower Abdomen CT Scan! The importance of early diagnosis with our modern medical imaging center services, accompanied by expert radiologists. Click for check-up packages!

Orbita CT Scan: Reliable medical imaging center. High-resolution MRI imaging, fast CT scans, and comprehensive radiology services. Protect your health with our check-up packages!

Examine your lungs in detail with a Thoracic CT Scan! Early diagnosis saves lives. Reliable medical imaging center. CT scan and MRI imaging services.

Detailed bone and joint examination with Extremity CT Scan! We are at your service with expert radiologists and advanced technologies for reliable results. Book your appointment now!

Detailed examination of the middle ear and surrounding bone structures with Temporal Bone CT Scan. Reliable medical imaging center solutions for early diagnosis.
Secure your heart health with Coronary CT Angiography! We are at your service with superior technology and expert medical staff for early diagnosis. All radiology services including MRI and CT scans.
High-resolution MRI imaging for brain, spine, joints, and soft tissue screening.
Safe and detailed cross-sectional imaging with low-dose radiation.
Fast and clear imaging for bone and lung screening.
Comprehensive health screening packages for early diagnosis and preventive care.
At our center, we provide MRI, CT, X-Ray, and Ultrasound services using state-of-the-art equipment. Our expert radiology team is here for the most accurate diagnosis.
Patient-Centered Care: Your comfort and health are our priority. We provide professional support at every step, from appointment to result delivery.
With our experienced radiology specialists and state-of-the-art equipment, we provide the highest quality imaging services for the most accurate diagnosis.
Thousands of our patients have met our quality service and friendly team.
Discover the latest developments in medical imaging and practical health insights.

Are you experiencing pituitary gland problems? Why is a pituitary MRI performed, and what should you pay attention to? Find all the answers you're looking for in this blog post!

Check your heart health without risk with coronary CT angiography! This non-invasive method offers unique advantages for early diagnosis and treatment.

Coronary CT angiography is a fast and effective method used to visualize the heart vessels. So, who should consider this important medical imaging technique? Here's the answer.